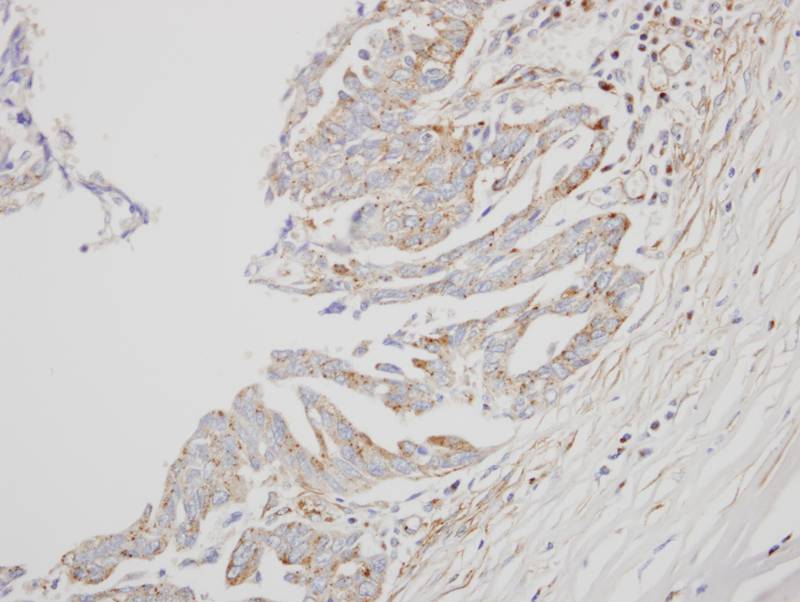
产品细节图片2

相关产品推荐更多 >
万千商家帮你免费找货
0 人在求购买到急需产品
- 详细信息
- 文献和实验
- 技术资料
- 免疫原:
Recombinant protein fragment contain a sequence corresponding to a region within amino acids 1 and 174 of Human IFNA8
- 形态:
liquid
- 保存条件:
Store at -20˚C
- 克隆性:
Polyclonal
- 适应物种:
Human
- 保质期:
12 months
- 抗原来源:
Rabbit
- 供应商:
南京赛戈巍生物科技有限公司
- 宿主:
Rabbit
- 应用范围:
WB IHC
- 抗体英文名:
Interferon alpha-8 antibody
- 规格:
50ul/100ul
应用详情:Predicted MW: 22kd
Western blotting: 1:500-1:3000
Immunohistochemistry: 1:100-1:250
图片:

Sample(30 ug whole cell lysate)
A: Raji
12% SDS PAGE
Primary antibody diluted at 1: 1000
,
Immunohistochemical analysis of paraffin-embedded OVCA xenograft, using interferon alpha 8 antibody at 1: 500 dilution.
风险提示:丁香通仅作为第三方平台,为商家信息发布提供平台空间。用户咨询产品时请注意保护个人信息及财产安全,合理判断,谨慎选购商品,商家和用户对交易行为负责。对于医疗器械类产品,请先查证核实企业经营资质和医疗器械产品注册证情况。
文献和实验Measuring Interferon Alpha and Other Cytokines in SLE
The progression of disease in patients with systemic lupus erythematosus (SLE) is affected by production, accumulation, and actions of cytokines. Type I interferon (IFN), specifically IFN-α, is recognized as a central mediator of disease
In situ hybridisation to alpha satellite sequences (chromosome specific)
Alpha satellite sequences, whilst highly repetitive, are specific to each individual chromosome. These sequences flank the centromeres and can present a target measured in megabases. In this protocol a biotin or digoxigenin labelled DNA
motifs located prevalently in the 3′ untranslated regions of target messenger RNAs (mRNA). Interferon-alpha-2a (IFNα) induces a large set of protein coding genes mediating antiproliferative and antiviral responses. Here we use a global microarray-based
技术资料暂无技术资料 索取技术资料





![PD L2 Rabbit mAb[52013]](https://img1.dxycdn.com/p/s14/2025/0922/498/0460884283108299691.jpg!wh200)

![CD24 Rabbit mAb[56960]](https://img1.dxycdn.com/p/s14/2025/0922/632/2321321568067599691.jpg!wh200)
![PP15 Conjugated Antibody[C47842]](https://img1.dxycdn.com/p/s14/2025/0923/305/2150219664296040791.jpg!wh200)
![CAMK4 Conjugated Monoclonal Antibody[C27103]](https://img1.dxycdn.com/p/s14/2025/0923/278/4431488150116040791.jpg!wh200)
